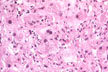

|
Fig 53 - DIFFUSE LOBULAR INFLAMMATION: Diffusely scattered mononuclear cell infiltration of the lobule especially in the perivvenular area. Lymphocytes and monocytes predominate but neutrophils, eosinophils and plasma cells may be present.
 |
Fig 54 - KUPFFER CELL HYPERPLASIA: With cells full of lipofuscin an bile, result of phagocytosis of disrupted hepatocytes. Nodules of these cells may persist after healing (late nodules of Spatknoetchen).
|
Fig 55 - LIVER CELL REGENERATION: Expressed by the presence of binucleate cells obviously due to increase rae of liver cell death. Mitoses are rare in the liver.
 |
Fig 56 - CENTRAL VEIN ENDOPHLEBITIS: In a case of fulminatinaute viral hepatitis..
 |
Fig 57 - DE-GLYCOGENATION: Injured cells lose their glycogen at very early stages. These same cells are those that release cytoplasmic enzymes in the serum. PAS stain. Glycogen stains red..
 |
Fig 58 - INTRACELLULAR AND CANALICULAR CHOLESTASIS: May be present and very prominent i certaincdinsha in tscaefcostti orm of viral hepatitis A.



